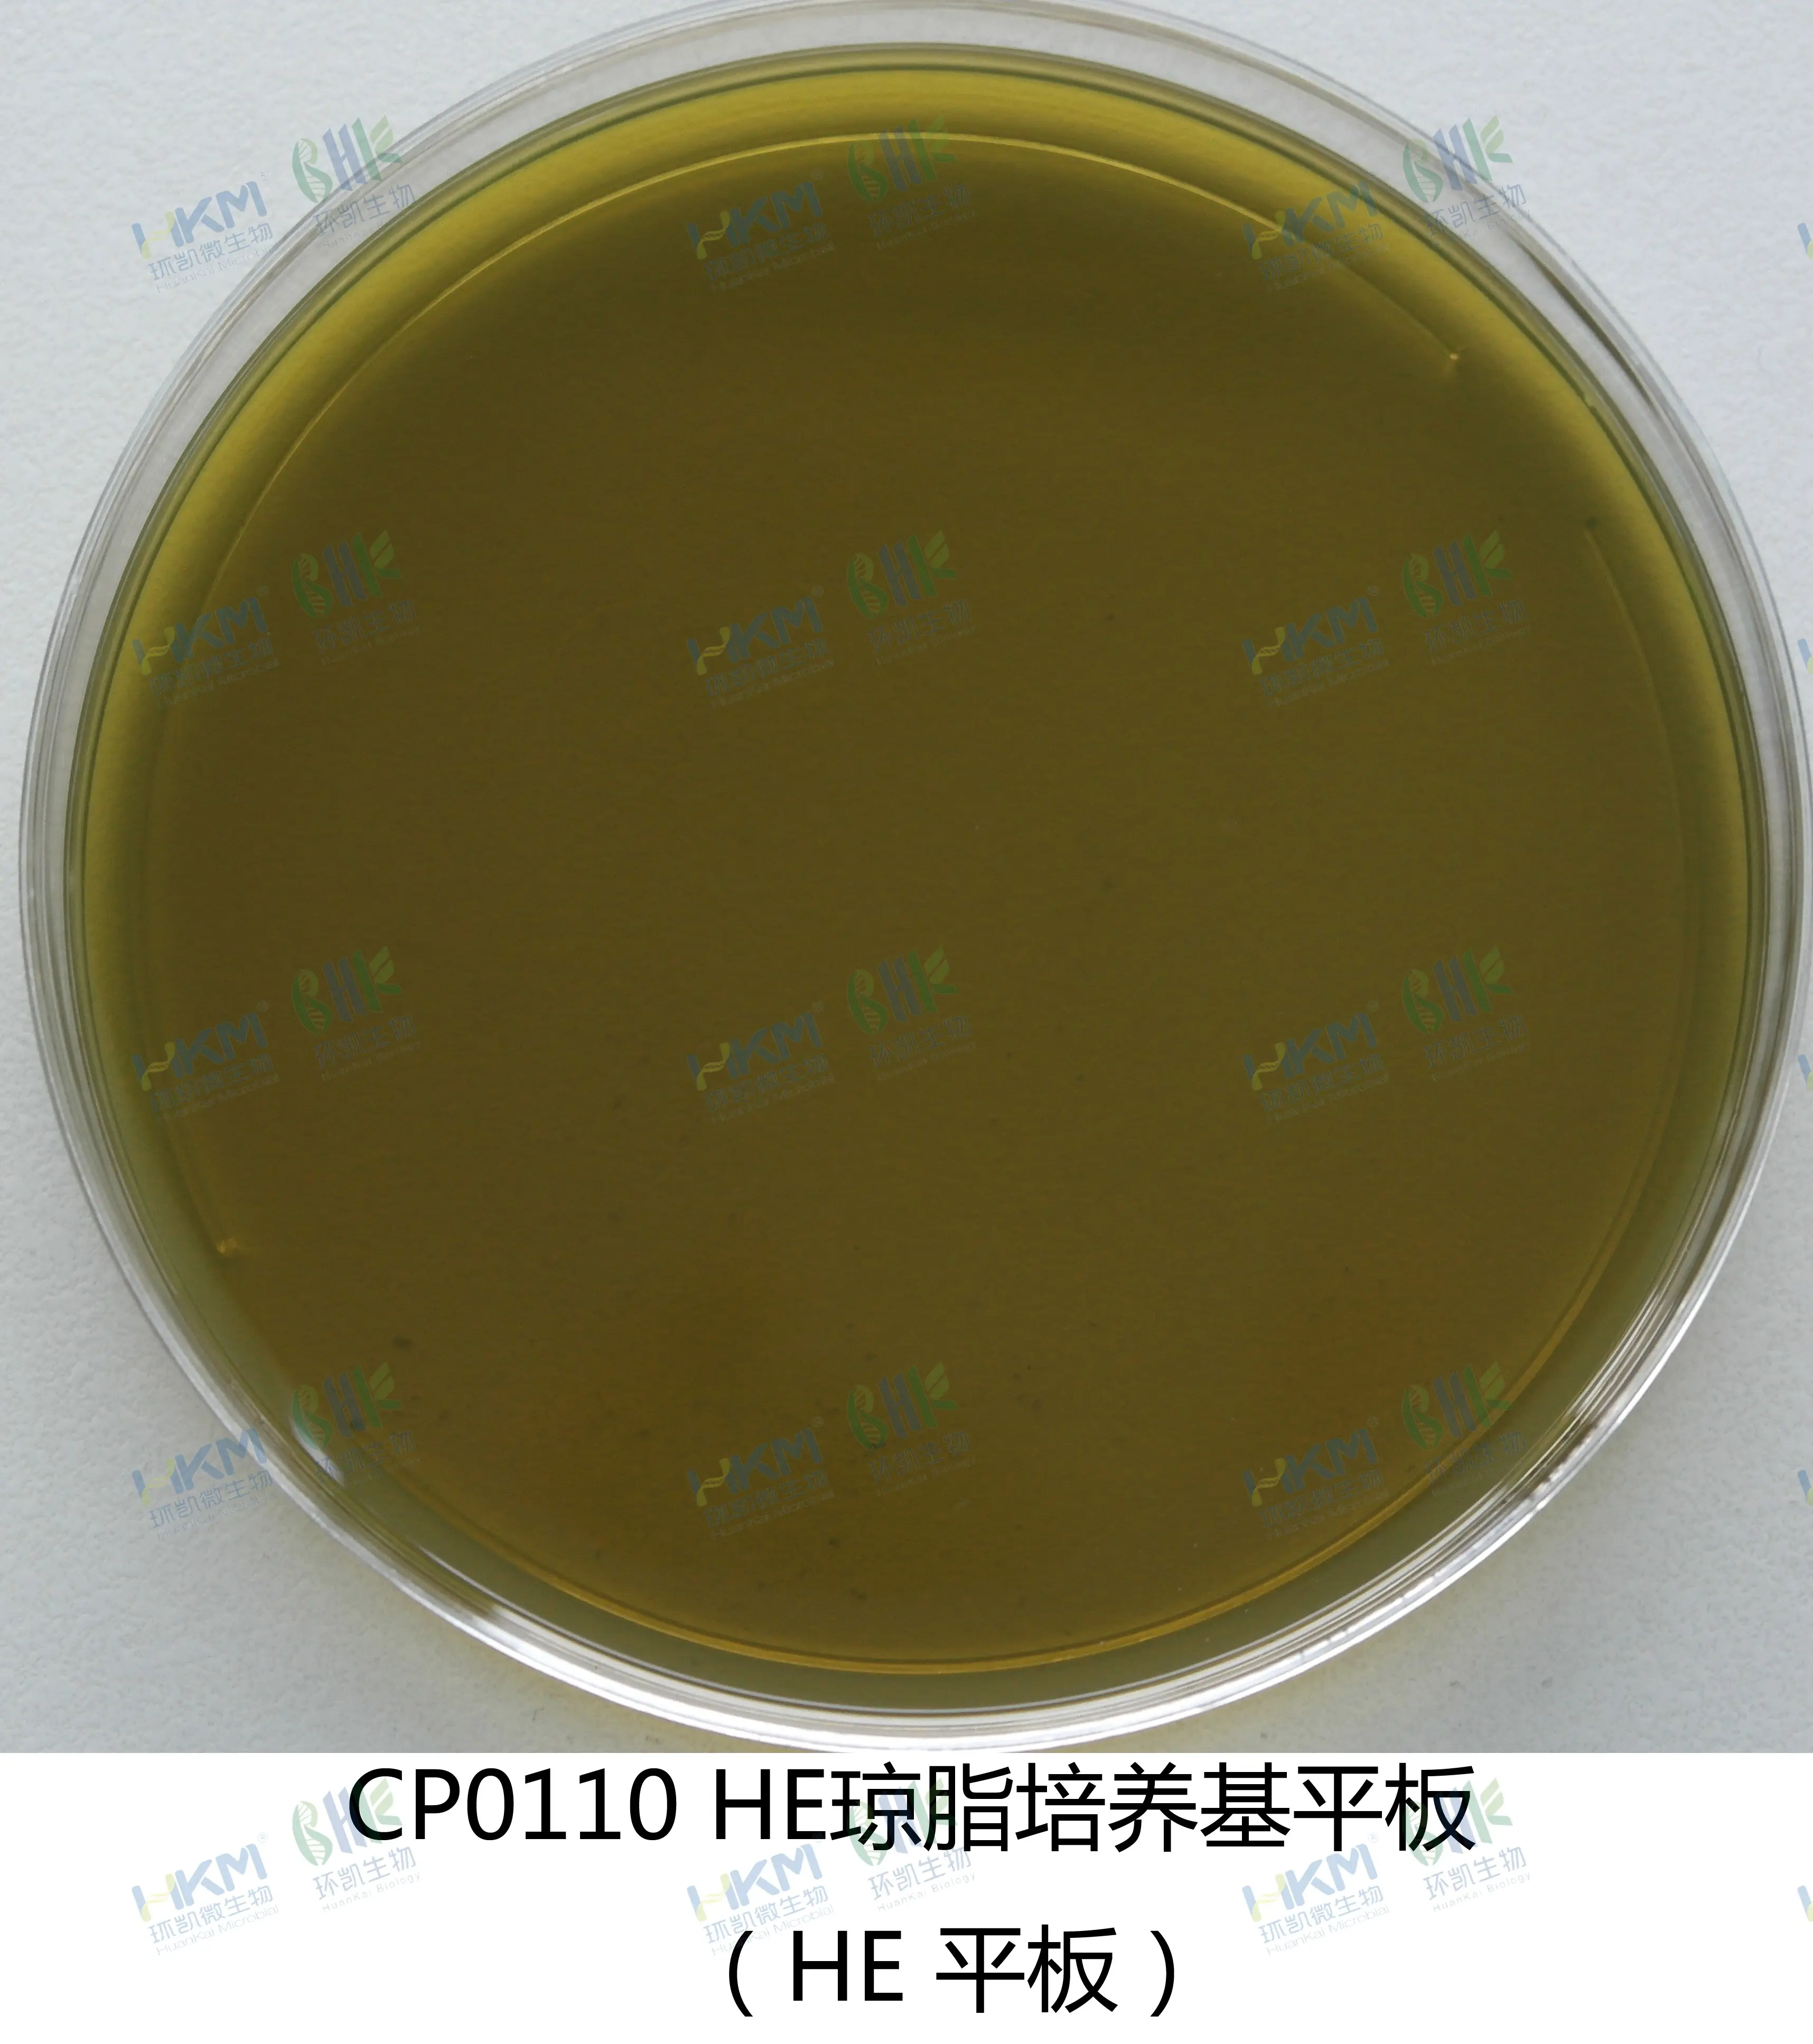
HE琼脂平板

商品详细
说明书
微生物图册
行业应用
相关论文
产品名称:HE琼脂培养基(平板)
英文名称:Hektoen Enteric Agar Plate
其它叫法:HE琼脂平板
产品编号与包装规格:
| 产品编号 | 产品类型 | 包装规格 |
|---|---|---|
| CP0110 | 即用型成品平板培养基 | 10皿/包,2包/盒 |
产品用途:用于肠道致病菌特别是沙门氏菌和志贺氏菌的选择性分离培养。
检验原理:蛋白胨、牛肉膏粉提供碳源、氮源、维生素和矿物质;乳糖、蔗糖和水杨素为可发酵的糖类;胆盐、去氧胆酸钠、溴麝香草酚兰和酸性复红抑制革兰氏阳性菌;氯化钠维持均衡的渗透压;硫代硫酸钠和柠檬酸铁铵用于检测硫化氢的产生,使菌落中心呈黑色;琼脂是培养基的凝固剂;溴麝香草酚兰和酸性复红为pH指示剂,发酵糖产酸的菌落呈橙-黄色,不发酵糖的菌落为蓝绿色。
HE琼脂平板配方成分:
| 配方 | 含量(每升) |
|---|---|
| 蛋白胨 | 12.0g |
| 牛肉浸粉 | 3.0g |
| 乳糖 | 12.0g |
| 蔗糖 | 12.0g |
| 水杨苷 | 2.0g |
| 胆盐 | 20.0g |
| 氯化钠 | 5.0g |
| 琼脂 | 15.0g |
| 溴麝香草酚兰 | 0.064g |
| 酸性品红 | 0.1g |
| 硫代硫酸钠 | 6.8g |
| 柠檬酸铁铵 | 0.8g |
| 脱氧胆酸钠 | 2.0g |
| 纯化水 | 1000mL |
| 最终pH 7.5±0.2 | |
使用方法:拆包即可使用。
HE琼脂平板质量控制【下列质控菌株接种待测试培养基, 35~37℃,24h结果如下:】:
| 指标 | 质控菌株及编号 | 标准值 | 特征性反应 |
|---|---|---|---|
| 生长率 | 鼠伤寒沙门氏菌ATCC14028或CMCC(B)50115 | PR≥0.5 | 绿-蓝色菌落,有黑心 |
| 福氏志贺氏菌CMCC(B)51572 | PR≥0.5 | 绿-蓝色菌落 | |
| 选择性 | 大肠埃希氏菌ATCC25922 | G<5 | 橙黄-橙红色菌落,有胆酸沉淀 |
| 粪肠球菌ATCC29212 | G≤1 | —— |
储存条件与保质期:2~25℃,避光保存;有效期见包装。
注意事项:即用型成品平板在2-8℃保存时与存放容器冷凝管保持一定距离以避免冻损坏,产品多次在低温与常温之间变更会引起琼脂的泌水,属于正常现象。使用前 应平衡至室温且尽量在无菌干燥箱中预干燥。
参考文献:GB 4789.4-2024 食品安全国家标准 食品微生物学检验 沙门氏菌检验。
本产品仅限于科研研究用途,不能用于医院和临床检测,购买者请知悉!













